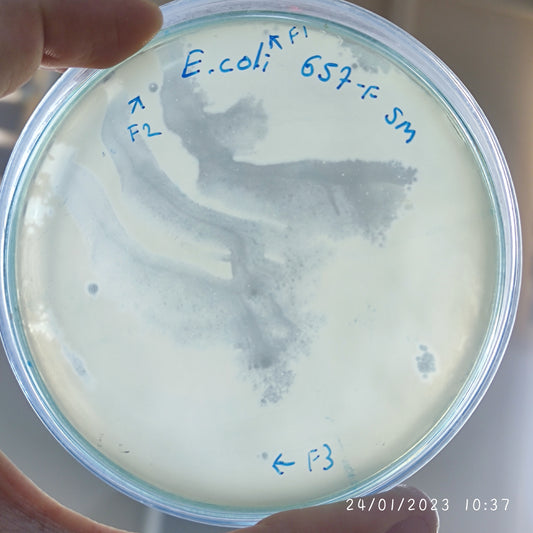
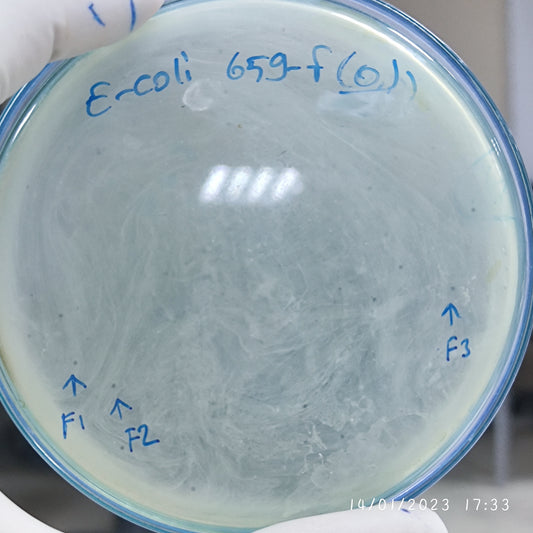
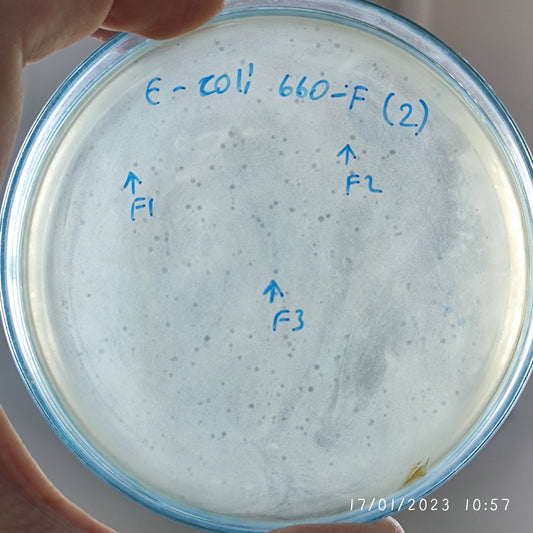
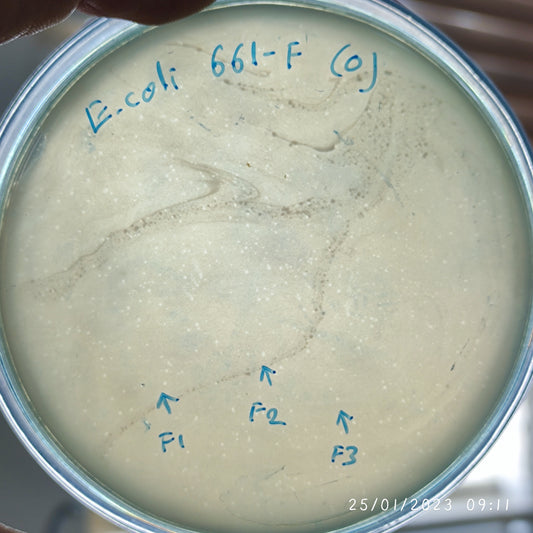
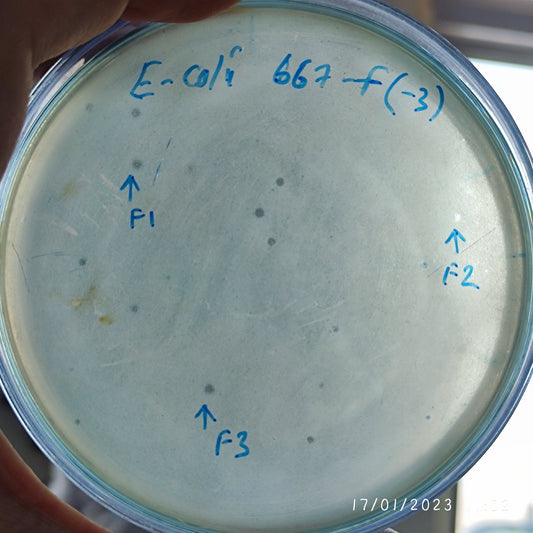
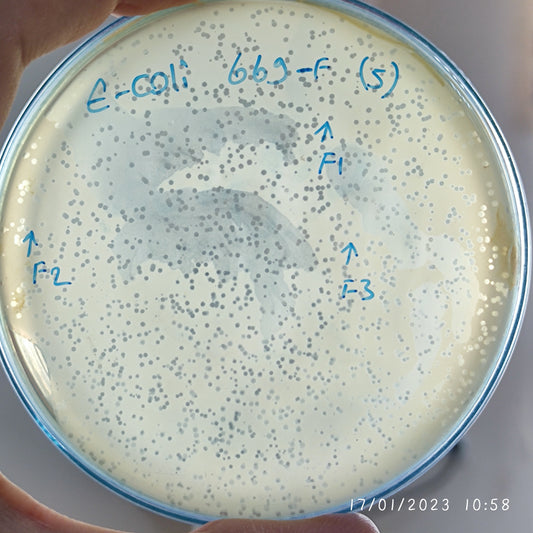
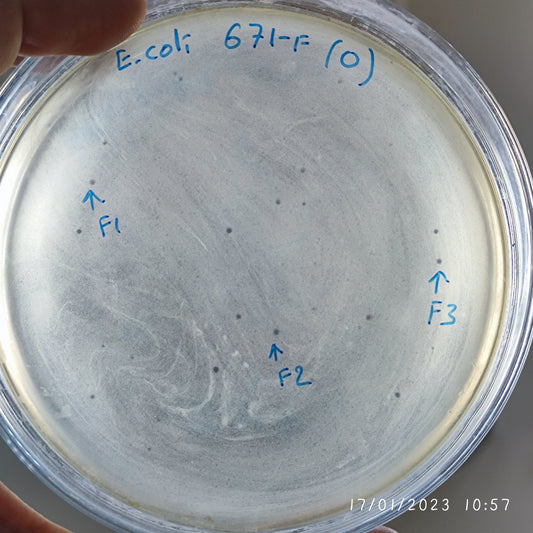
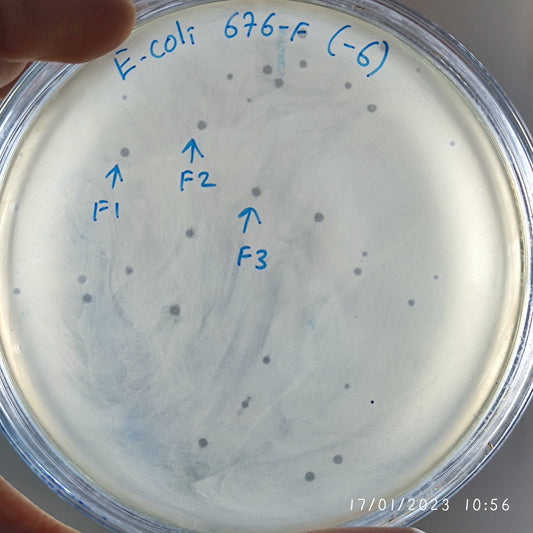
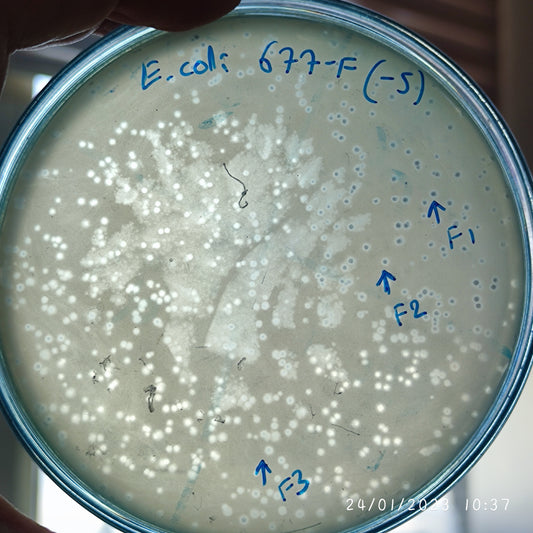
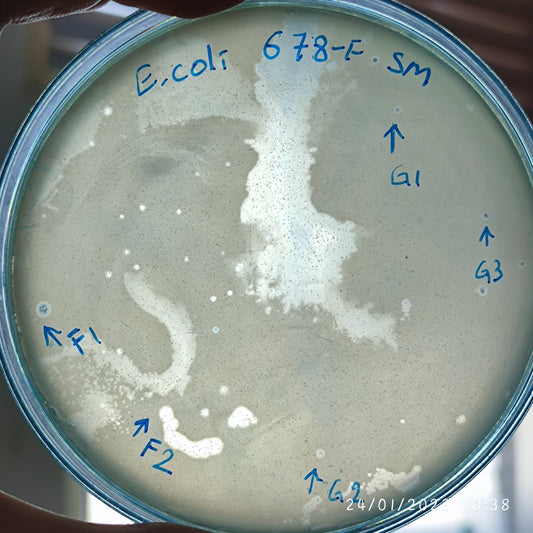

-
Escherichia coli bacteriophage 100657F
Regular price $750.00 USDRegular priceUnit price per -
Escherichia coli bacteriophage 100659F
Regular price $500.00 USDRegular priceUnit price per -
Escherichia coli bacteriophage 100660F
Regular price $500.00 USDRegular priceUnit price per -
Escherichia coli bacteriophage 100661F
Regular price $750.00 USDRegular priceUnit price per -
Escherichia coli bacteriophage 100667F
Regular price $500.00 USDRegular priceUnit price per -
Escherichia coli bacteriophage 100669F
Regular price $600.00 USDRegular priceUnit price per -
Escherichia coli bacteriophage 100670F
Regular price $500.00 USDRegular priceUnit price per -
Escherichia coli bacteriophage 100670G
Regular price $600.00 USDRegular priceUnit price per -
Escherichia coli bacteriophage 100671F
Regular price $500.00 USDRegular priceUnit price per -
Escherichia coli bacteriophage 100672F
Regular price $500.00 USDRegular priceUnit price per -
Escherichia coli bacteriophage 100674F
Regular price $600.00 USDRegular priceUnit price per -
Escherichia coli bacteriophage 100675F
Regular price $500.00 USDRegular priceUnit price per -
Escherichia coli bacteriophage 100675G
Regular price $500.00 USDRegular priceUnit price per -
Escherichia coli bacteriophage 100676F
Regular price $500.00 USDRegular priceUnit price per -
Escherichia coli bacteriophage 100677F
Regular price $750.00 USDRegular priceUnit price per -
Escherichia coli bacteriophage 100678F
Regular price $750.00 USDRegular priceUnit price per